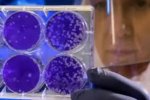
Infeksi virus Nipah

Skip to main content
-
- Berita
- Finansial
- Digital
- Ekonopedia
- Ekonomi Hijau
- Jurnalisme Data
- In-Depth & Opini
- Video
- Podcast
- Otomotif
- Info
- Indeks
©2026 Katadata. Hak cipta dilindungi Undang-undang.